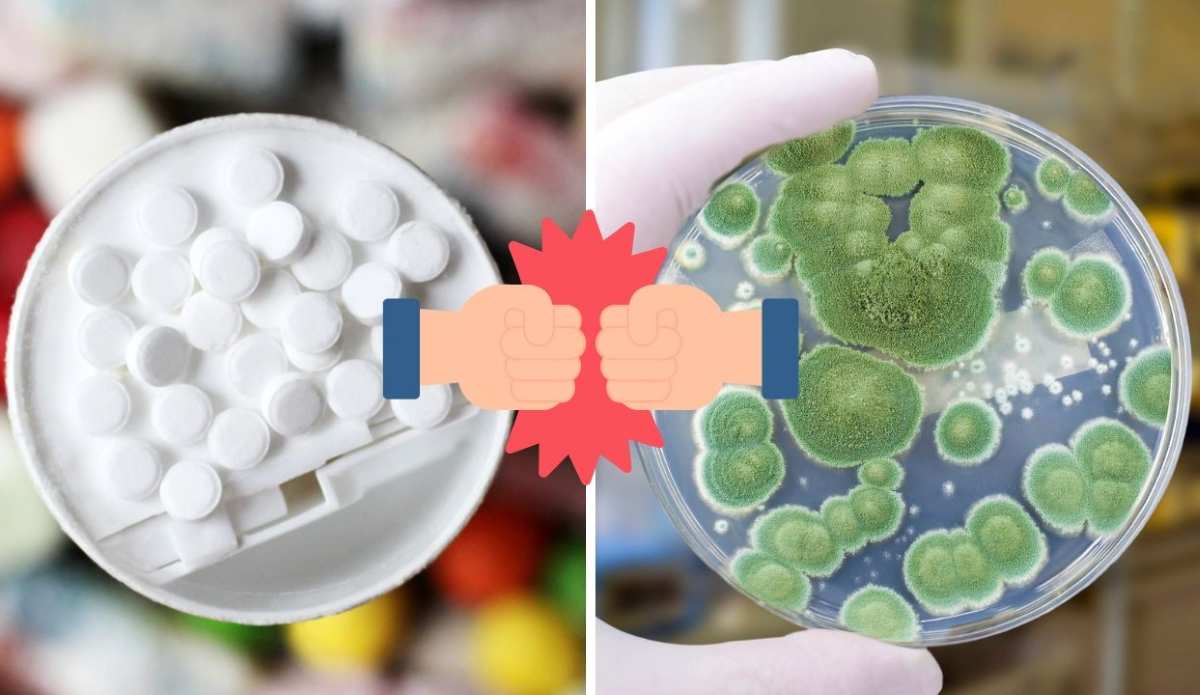

Nuevo estudio descubre que la sacarina, un edulcorante artificial común, puede destruir algunas de las bacterias más peligrosas del mundo

La sacarina podría pasar de ser un simple edulcorante a convertirse en una herramienta poderosa en la lucha contra la resistencia bacteriana, un problema que afecta a todos.
- Sacarina destruye bacterias peligrosas.
- Mejora el efecto de antibióticos.
- Rompe paredes bacterianas y altera su ADN.
- Impide formación de biofilms resistentes.
- Útil en tratamiento de heridas.
- Alternativa frente a la resistencia antimicrobiana.
La sacarina, un edulcorante que podría revolucionar la lucha contra bacterias resistentes
Un aliado inesperado en la medicina moderna.
La sacarina, un edulcorante artificial presente en productos bajos en calorías desde hace más de un siglo, podría convertirse en una herramienta clave contra algunas de las bacterias más peligrosas del mundo. Una investigación liderada por el profesor Ronan McCarthy en la Universidad de Brunel, Londres, ha revelado que esta sustancia no solo es segura para el consumo humano, sino que también puede destruir bacterias resistentes a los antibióticos.
Un problema de salud global: la resistencia antimicrobiana
La resistencia antimicrobiana (RAM) ya causa más de 1,27 millones de muertes al año, y está implicada en casi 5 millones de fallecimientos. Bacterias como Acinetobacter baumannii y Pseudomonas aeruginosa son particularmente peligrosas en hospitales, donde atacan a pacientes inmunodeprimidos. Estas cepas, capaces de resistir múltiples tratamientos, figuran entre las amenazas más urgentes según la Organización Mundial de la Salud.
¿Cómo actúa la sacarina contra las bacterias?
La sacarina rompe la estructura de la pared celular de las bacterias, lo que provoca que se deformen, estallen y mueran. Este daño físico facilita la entrada de antibióticos al interior de la célula, potenciando su efecto.
Además, interfiere con procesos internos críticos, como la replicación del ADN. Las bacterias tratadas con sacarina se alargan, dejan de dividirse y su ADN empieza a replicarse descontroladamente, fuera de los sitios normales de inicio y término. Este caos genético puede deberse a mecanismos de reparación del ADN activados de forma anómala.
Desactiva su sistema de defensa
La investigación también mostró que la sacarina altera las proteínas que protegen la membrana externa de las bacterias. Como resultado, se forman bultos anómalos en las paredes bacterianas que terminan por romperse, un efecto similar al de los antibióticos β-lactámicos.
Eficaz contra biofilms y cepas resistentes
Las bacterias suelen agruparse en biofilms, capas pegajosas difíciles de eliminar con antibióticos. La sacarina impide la formación de nuevos biofilms y descompone los ya existentes, incluso en ambientes con múltiples especies bacterianas. Al combinarse con antibióticos como los carbapenémicos, la resistencia de bacterias como A. baumannii disminuyó significativamente.
Aplicación directa: tratamiento de heridas
En pruebas de laboratorio con piel de cerdo, se usaron hidrogeles con sacarina para tratar quemaduras. El resultado fue notable: menos infecciones que con apósitos de plata, actualmente usados como estándar.
Potencial de esta tecnología para hacer nuestro mundo más sostenible
La sacarina puede reducir el uso de antibióticos, lo que ayuda a frenar la aparición de nuevas resistencias. Al ser un producto ya aprobado para consumo humano, aceleraría su implementación clínica sin grandes costes. Además, su uso en tratamientos localizados como apósitos puede evitar tratamientos sistémicos innecesarios, disminuyendo el impacto ambiental del uso masivo de antibióticos en medicina y agricultura.
Más información: Saccharin disrupts bacterial cell envelope stability and interferes with DNA replication dynamics | EMBO Molecular Medicine